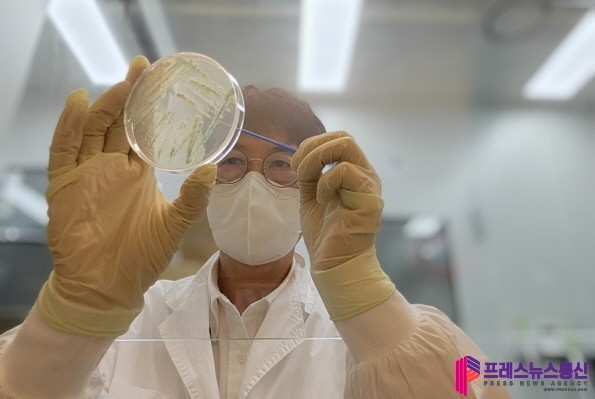

- 85도 이상 조리, 상처 보호, 비누 세척 등 예방수칙 강조
- 지난해 보다 1주일, 2023년보다는 약 1달 정도 늦게 검출
|
| ▲비브리오패혈증균 분리사진(사진=경기도) |
[프레스뉴스] 장현준 기자= 경기도보건환경연구원은 5월 20일 채수한 해수에서 비브리오패혈증균(Vibrio vulnificus)이 검출됐다며 주의를 당부했다. 올해는 2023년보다 약 한 달 정도, 2024년보다는 1주일 정도 늦게 검출됐다.
비브리오패혈증은 주로 5~6월에 발생해 8~9월에 가장 많이 나타나며, 어패류를 생식하거나 피부 상처에 오염된 해수가 닿으면 감염될 수 있다.
최근 3년간 경기도 감염 사례는 2022년 13명, 2023년 9명, 2024년 16명으로 집계됐다.
비브리오패혈증은 감염 시 급성 발열, 오한, 복통, 구토, 설사 등의 증상이 나타나고, 피부에는 부종, 발진, 괴사성 병변 등이 생길 수 있다. 특히 만성 간질환자, 당뇨병 환자, 면역저하자, 알코올 중독자 등 고위험군은 감염 시 치명률이 높아 각별한 주의가 필요하다.
비브리오패혈증균은 염도 1~3%의 해수에서 증식하는 호염성 세균이므로, 어패류 섭취 시 반드시 흐르는 수돗물에 세척한 후 85℃ 이상에서 충분히 가열 조리해야 한다. 해양 활동 시에는 피부에 상처가 생기지 않도록 주의하고, 물놀이 후에는 비누를 사용해 깨끗이 씻는 것이 중요하다.
경기도보건환경연구원 전종섭 수인성질환팀장은 “비브리오패혈증은 조기 예방이 무엇보다 중요한 질환”이라며 “어패류 반드시 익혀 먹기, 조리 시 장갑 착용, 상처가 있을 경우 바닷물 접촉 금지 등 예방 수칙을 철저하게 지켜달라”고 당부했다.
[저작권자ⓒ 프레스뉴스. 무단전재-재배포 금지]
댓글 0

경기남부
[기획 보도] 안산시, 병오년 새해 시민 삶의 질 높이는 7대 정책 변화 제시
장현준 / 26.01.17

문화
농림축산식품부, 충남 당진 산란계 농장 고병원성 조류인플루엔자 발생에 따라 방역관...
프레스뉴스 / 26.01.16

사회
김영록 전라남도지사, 순천대 대학 통합 투표 찬성 결정 환영
프레스뉴스 / 26.01.16

정치일반
이재명 대통령, 21일 신년 기자회견…청와대 복귀 이후 처음
프레스뉴스 / 26.01.16

정치일반
이재명 대통령, 중장 진급·보직신고 및 수치 수여식 개최
프레스뉴스 / 26.01.16




















































